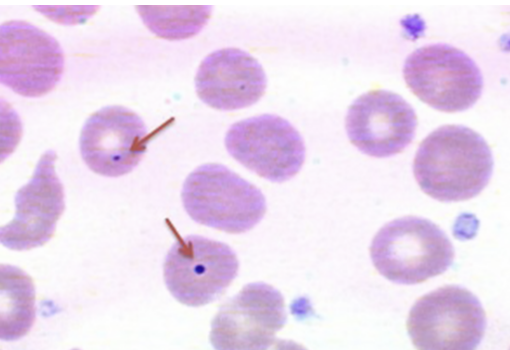

How do you differentiate between infantile spasms and colic? [1]
In infantile spasms the child will become distressed between spasms, whereas in colic the child will become distressed during the ‘spasms’
A patient has acute rheumatic fever.
How do you treat? [2]
Stat dose of IV benzylpenicillin
- followed by oral abx
Dermatomyositis is associated with the [] antibody
Dermatomyositis is associated with the anti-Jo-1 antibody
What dx test would indicate compartment syndrome? [1]
Compartment syndrome produces pain on passive stretch
What is the main finding on the x-ray?
Salter-Harris type 1 fracture
Salter-Harris type 2 fracture
Salter-Harris type 3 fracture
Salter-Harris type 4 fracture
Salter-Harris type 5 fracture

Salter-Harris type 3 fracture
What is a poor prognostic factor for CDH? [1]
The presence of the liver in the thoracic cavity is a poor prognostic factor for CDH
Tx for Bell’s palsy? [1]
Oral prednisolone in 72hrs of onset of sx
Which two cardiac conditions are most common in Turner’s syndrome? [2]
- Which is most common? [1]
Bicuspid aortic valve - most common
Coractation of aorta
No 1 cause of gastroenteritis in children? [1]
Novovirus
A patient has ?Coeliac’s disease.
What result would you see on a blood film [1]
Why? [1]
Howell-Jolly Bodies
- due to hyposplenism
How might you detect a paradoxical embolism? [1]
With a bubble-echo
- ultrasound test where tiny bubbles are injected into the bloodstream to help visualize blood flow through the heart. It’s primarily used to detect right-to-left shunts, such as a patent foramen ovale (PFO), which can be a cause of stroke or transient ischemic attack (TIA)
What type of mole is this? [1]

Intra-dermal naevi
- elevated and pale
- develops from compound naevi
When is inteferon beta indicated in MS? [1]
If RRMS and can walk
[2] are the target antigens in pemphigus vulgaris
Desmoglein-1 and desmoglein-3 are the target antigens in pemphigus vulgaris
How do you differentiate between the presenting features of polymyalgia rheumatica and polymyositis? [1]
Polymyalgia rheumatica causes bilateral proximal muscle pain, but weakness is not a prominent feature
Polymyositis occurs in the elderly and causes bilateral, proximal muscle weakness, usually without pain. Muscle bulk is preserved until late in the disease
GBS causes upper / lower motor changes? [1]
Lower
Describe the vomiting type in pyloric stenosis [1]
White / not bilous
- Bilous would indicate intestinal malrotation
Scaphoid fracture w [] = urgent surgical fixture? [1]
Scaphoid fracture w proximal pole fracture
How do you differentiate between subacromial bursitis and adhesive capsulitis? [1]
Pain with active abduction of the shoulder at 60-120 degrees with reduced range of motion is typical for subacromial bursitis.
- acute presentation
Adhesive capsulitis is also know as frozen shoulder syndrome as there is inflammation of the glenohumeral joint causing restricted passive and active shoulder movements in all directions.
- chronic presentation
- associated with DM / thyroid disease / RA
Describe what is meant by Mittelschmerz and how it presents [2]
Mittelschmerz is mid-cycle ovulatory pain
- due to rupture of the Graafian (dominant) follicle, each month, which results in the release of an ovum into the fallopian tube.
- pain can vary from side to side
- Duration of pain can vary from minutes up to a few days
In most patients with endometriosis, the transvaginal ultrasound scan shows what findings [1]
In most patients with endometriosis, the transvaginal ultrasound scan is normal.
The triad in The triad in Juvenile Myoclonic Epilepsy (JME) consists of [3]
The triad in Juvenile Myoclonic Epilepsy (JME) consists of myoclonic jerks, absence seizures, and generalized tonic-clonic seizures (GTCS)
A patient has a SAH.
What is treatment can be used to stop vasopasm? [1]
Nimodipine




